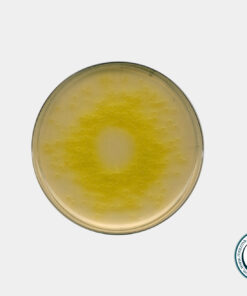
محیط کشت ستریماید آگار مرک کد 105284\ فروشگاه اینترنتی مستر آزما

محیط کشت سترماید آگار
محیط کشت ستریماید آگار یکی از محیط کشتهای مناسب برای تشخیص سودوموناس آئروژینوزا است. این محیط برای اولین بار توسط فردی به نام Lowburry توسعه داده شد. سپس به مرور زمان اصلاح گردید. فروش/خرید و قیمت محیط کشت ستریماید آگار در فروشگاه مواد شیمیایی/آزمایشگاهی مسترآزما فقط در بسته بندی استاندارد شرکت سازنده (مرک-سیگما) صورت میگیرد.
این محیط برای جداسازی انتخابی و شناسایی سودوموناس آنروژینوزا تعبیه شده است. محیط کشت ستریماید آگار دارای فرمولی با تکنیک آگار است که بااضافه کردن ستریماید (استیل تری متیل آمونیوم برمید)برای مهار انتخابی ارگانیسم های غیراز سودوموناس آنروژینوزا اصلاح شده است.
ستریماید یک نمک آمونیوم کواترنر است که به عنوان یک شوینده کاتیونی عمل می کند. اقدامات مهار کننده کشش سطحی را در نقطه تماس گرفته و دارای اثرات رسوبی پیچیدگی و دناتوره بر روی پروتئین های غشای باکتریایی است.
لازم به ذکر است که برای جداسازی Pseu.aeruginosa باید نمونه های موجود را از محیط T.S.B یا برین هارت اینفیوژن براث به محیط ستریماید آگار انتقال پیدا کند. کلنی های رشد کرده به رنگ آبی متمایل به سبز و یا بی رنگ می باشند.
پپتون ژلاتین مواد مغذی لازم را برای P.aeruginosa فراهم می کند. سدیم کلرید تعادل اسمزی را حفظ می کند. منیزیم کلرید و پتاسیم سولفات تولید پیوسیانین را تحریک می کند.
برای اطلاعات بیشتر در مورد محیط کشت ها میتوانید مقاله محیط کشت ها چه هستند؟ در بخش مقالات علمی فروشگاه مسترآزما را مطالعه کنید.
مواد تشکیل دهنده محیط کشت ستریماید آگار
- پپتون ژلاتین
- منیزیم کلرید
- پتاسیم سولفات
- سدیم کلرید
- ستریماید
- آگار
کاربردهای محیط کشت ستریماید آگار
- در تشخیص سودوموناس آئروژینوزا
- در بررسی لوازم ارایشی بهداشتی
- جهت جداسازی انتخابی باکتری گرم منفی
- جهت افزایش تولید رنگدانه
- در ارزیابی اثر ضدعفونی کننده ها
فروش ستریماید آگار مرک کد 105284
فروشگاه مستر آزما به عنوان یکی از تامین کنندگان پیشگام محصولات شیمیایی و محیط های کشت از معتبرترین برندهای جهان آماده تامین و عرضه محیط کشت با کد 105284 با کیفیتی عالی و قیمتی رقابتی در مقادیر مختلف از کمپانی معتبر شرکت مرک – سیگما آلمان می باشد.
این کالا به همراه برگه آنالیز و ضمانت اصالت کالا به فروش می رسد.

دیدگاهها
هیچ دیدگاهی برای این محصول نوشته نشده است.